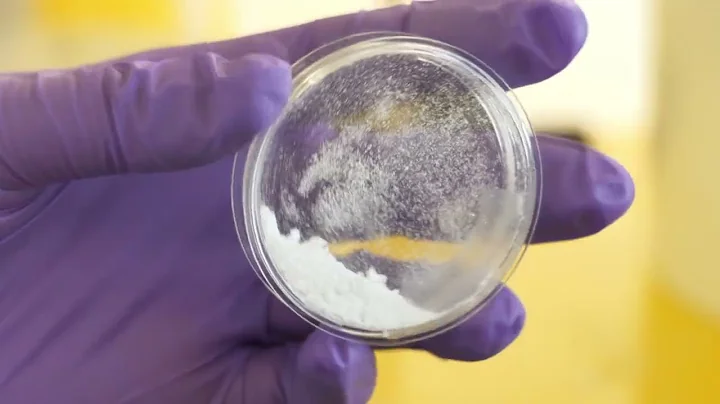
ABTC: Powering the Future of Sustainable Energy

External Source
The Future Of Battery Recycling Extracting Valuable Materials For Sustainable Energy Storage
Synopsis
The video effectively delivers valuable content about the speaker's expertise in batteries and energy storage. This would help the ...
Download Options
Choose a download method below. All links open in new tabs.
| Service | Features | Action |
|---|---|---|
| SaveFrom |
MP4 & MP3 • HD Quality • Browser Extension Available
|
Download |
Security Notice: These are third-party services. We recommend using antivirus software and being cautious of pop-up ads.